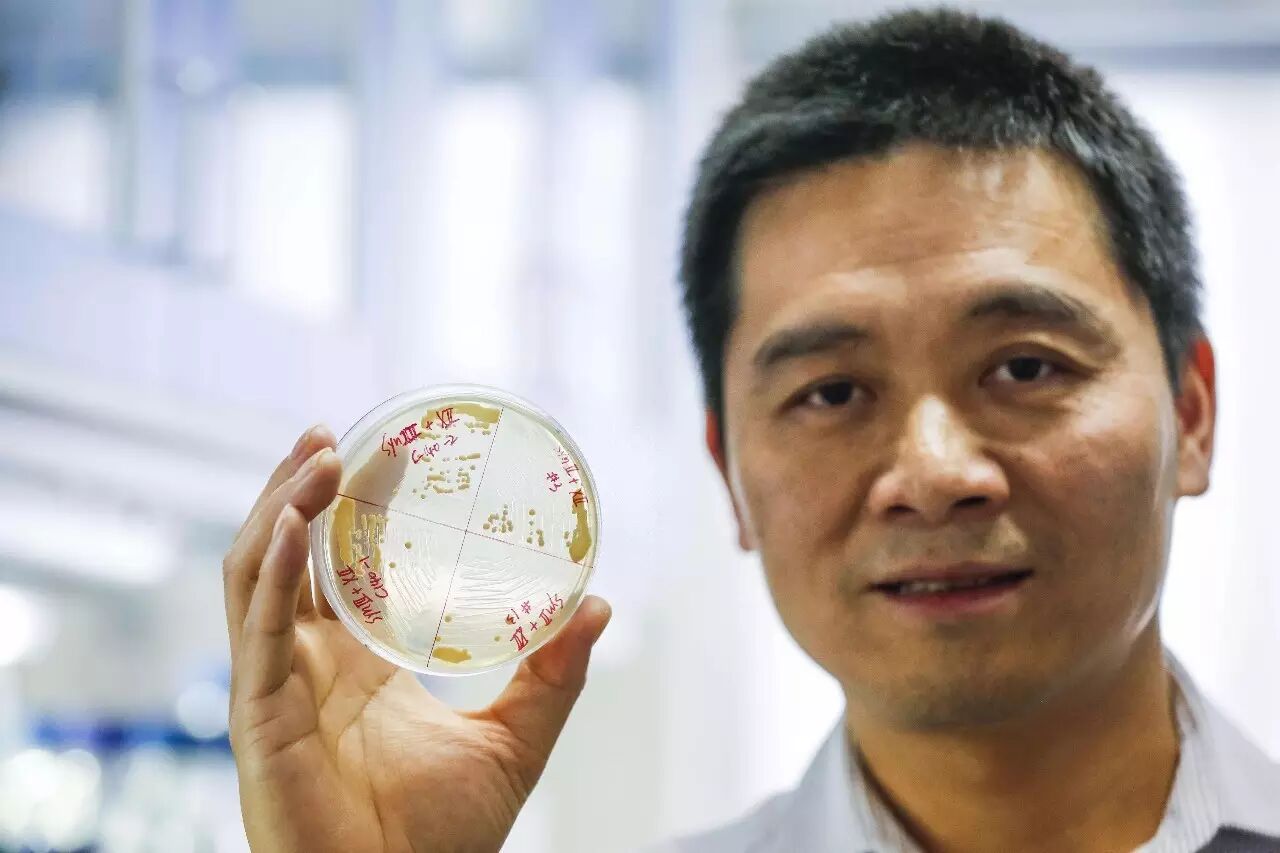
eicZhoGYCfybBVBlsSdpqnTAK1mnCPaXb9n7nibibr0RE38drrFNAZyg5t45K7CLOaIX6BCljxJwzrWz2ngUkGibgw

《大咖论健》特刊总第21期
戴俊彪 博士

精准医学作为“十三五”重大专项,上游基因等技术成本降低,近百万人群队列专项启动,微生物组、免疫治疗、单细胞、基因编辑和合成等新技术突飞猛进;下游在医疗健康、工业生产等应用范围扩大,跨界巨头进入,并购开始;同时,应用边界、行业规范、伦理体系尚需完善。“健康所系,性命相托”,在行业关键进程节点,如何传播专业的发声,促进各方连接?
作为精准医学行业变革的连接器,基因慧策划和主办《大咖论健》,邀请行业代表先锋传播前沿信息,建立行业品牌。“使连接产生价值,让知识获得尊重”,助力行业有序发展。(感谢动脉网媒体支持)。
【往期回顾】
特刊 总第21期
【编者按】从“读”到“写”,从理解到构建,从1999年人类基因组计划(HGP)到2016年人类基因组编写计划(HGP),基因产业逐渐形成闭环,合成生物领域,从189年前合成有机物尿素、到52年前合成牛胰岛素蛋白质、到9年前J. Craig Venter合成原核生物基因组,到如今合成真核生物基因组:酵母,科技的进步速率追上众人的想象力。近日,国际核心科研期刊《Science》以封面和专刊形式报道了合成基因组的系列进展及七篇论文。下面我们邀请其中的论文通讯作者戴俊彪博士——十年如一日专注酵母和合成基因组领域,听他说合成基因组的技术路线和产业应用。
作者:戴俊彪 博士
清华大学生命科学学院

人工合成酵母基因组计划的背景
【基因慧】:戴老师,您好!感谢您接受基因慧的专访。祝贺“人工合成酵母基因组合成计划(Sc2.0 Project)”在《Science》以封面、专刊形式发表[1,2]。您本人在2008年也发表在《细胞》杂志上的论文被选作封面文章[3]。作为合成生物学领域的科学家,请您向基因慧读者介绍下自己,以及谈谈Sc2.0项目的背景。
【戴俊彪】:我先介绍一下我自己的简单背景。我是1993年进入南京大学基础学科教学强化部,97年毕业到了清华读生物科学与技术系硕士,2000年去美国的爱荷华州立大学读PHD,导师是DanielF. Voytas,他在基因组编辑领域非常知名,尤其在植物基因组编辑方面,现在已经转到了明尼苏达大学。在我读完博士以后,2006年我加入了约翰霍普金斯大学医学院的Jef D. Boeke的实验室。他是酵母Sc2.0计划最初的提出者和主要领导者。在Jef D. Boeke实验室我同时做了两个project。一个就是我们2008年发表在《Cell》上的文章。 另外一个是参与Sc2.0(人工合成酵母基因组计划)最初部分的工作。Sc2.0的第一篇文章于2011年发表在Nature [4],当时还没有Sc2.0这个名字。在这篇文章里面,介绍了我们对整个合成染色体的设计工作。
2011年,我从约翰霍普金斯大学结束了博士后,回到了中国并在清华建立了我自己的实验室。我博士期间做的课题是研究酵母的一个逆转座子的作用机制,到了博士后做了一些蛋白相关的研究,到了自己建实验室的时候又重新开始了做人工合成酵母基因组计划。在英国爱丁堡大学博士后Yizhi Patrick Cai的推动下,2012年初我们在清华附近组织第一次Sc2.0的项目协调会,邀请了来自英国,澳大利亚,新加坡、香港以及印度的科学家和基金机构。在这个会上,我们讨论了如何进行这项国际合作。于是开始有了Sc2.0 计划。所以,从2012年开始,我国的三个组正式开始Sc2.0计划。

图:参与国际酿酒酵母基因组合成计划的中国科学家代表,自左至右依次为:李炳志、戴俊彪、杨焕明、元英进、沈玥。(图片来源:人民网)
合成基因组的研究初心和技术进步
【基因慧】:看到您在2003年以及更早前开始研究酵母的逆转录病毒元件控制,到今年人工合成酵母全基因组,您能谈谈合成基因组的研究目的是什么?这14年一路走来,请您和大家介绍下合成基因组领域发生了怎样的变化和进步呢?
【戴俊彪】:我先谈谈这个Sc2.0计划研究的目的。如果把我们的细胞当作是一个房间,我们现有的基因组决定了我们这间房间里面的布局。比如这有个窗户,那边放一台电视机,这边安一个插座。我们通过测序技术得到基因组序列,了解到编码这样布局的决定因素。那么,合成基因组的主要目的是想知道:基因组是怎样决定出这个布局?那怎么能够知道呢?拿一个简单的方式比喻就是把这边墙壁打开来看看它里面是怎样的?那边把它挖出来看看里边的线是怎么样去布的,然后我们再依样做一个。所以通过这样的一个构建过程,使得我们可以对基因中怎样去决定有一定的了解,这是合成生物学中一个最核心的理念叫build to understand,就是说通过构建来帮助我们理解。
合成生物学的第二个目的在我们先通过构建理解了之后,我们怎么样去设计基因组?就像房子的比喻来说,基因组决定了现在的装修风格,比如窗户、电视在房子中的位置。那么我能不能改变这个装修风格,把这边的窗户封了在那边开个窗户呢?随着技术的进步,这是有可能的,从2000年起,我们能够建立一个小的基因线路,实现一个设定的功能,比如说让细胞一会发荧光一会儿不发荧光,实现这种周期性的变化。到2016年,我们已经可以设计出来一个比较复杂的的基因线路,实现多步的调控,所以这个领域的发展还是很大的。另外一个方向,我们从最小的病毒基因组合成开始,一直到2010年CraigVenter他们合成的支原体,到现在酵母基因组的合成,这都是很大的变化。同时,基因合成的价格从几美元一个碱基降到了现在几美分一个碱基,这是一个非常巨大的变化,几乎有一百倍的价格下降。
合成基因组的技术路线
【基因慧】:在Sc2.0计划中,您的团队主要负责攻克16条染色体中长度最长、功能最为特殊的十二号染色体的人工合成,其中用到了分层组装和后续改造。您能用相对比较通俗的话和大家详细讲讲,基因组合成和改造的技术路线吗,其中的重难点是什么呢?
【戴俊彪】:染色体组装里面我们有一个设定好的策略。我们合成染色体并不是从一个个碱基一直加,而是我们把它分成了几个片段,每一片段作为一部分合成,然后再把所有的片段加起来。对于其中的每一片段,我们利用化学合成,获得长度约为八十到一百个的碱基或字符的核苷酸链,然后把它们拼接形成的。这就造出了我们构建染色体的一块一块的砖。染色体的组装策略就像是造一堵墙,通过一块块这样的砖给拼接起来的。第一块接着第二块,第二块接着第三块,形成一条完整的染色体。我们用自己重新造的砖去取代原本已经在那个染色体上同样的位置的这一块砖,从左到右,一块一块的这样取代过去直至把所有的取代完。
这个策略对于短的、只需几块砖便可以垒成的染色体比较容易完成。但对于酵母基因组中长的染色体,差不多一百万个碱基,需要用大约三十三块这样的砖给垒起来,就比较困难了。因为其中每一块砖都是设计的,我们不确定这块砖是不是可以执行它的功能?也就是说,我们不知道它能不能把它原来那块转给取代掉。比如,我们设计的砖里面加的一些东西是否会导致这块砖受压就碎了。所以我们才发展了“分级组装”方案。简单的比喻,我们把这个三十三块砖放在三十三个菌株里面,先把每一块砖都相应的整合进去作为一个测试,这样我们就可以拿到三十三个这样的染色体,每个染色体都不是整条都被取代了,而是只有那一块砖被取代为合成的。在这个基础上我们就可以找出来所有可能发生问题的这个砖块在哪里?而实际上我们也确实发现了很多个砖块的确有问题。所以我们就在测试完后去把这上面的问题给修复掉,修复完再用新设计好的砖再去取代掉原来那一块。然后我们再把这三十三块砖在六个不同的菌株里面,每个菌株五块的分别组装起来,然后把这六个菌株通过酵母交配变成二倍体,再通过减数分裂变成单倍体的办法,把这些合成的砖块拼接到同一个染色体上去。
合成基因组的重难点
【戴俊彪】:寻找到砖块里的问题是我们碰到的最大难点。因为我们曾经在某一砖快整合进去的时候,被卡了差不多一年时间。因为以前的设计是从左到右一个个砖块往下,这块地方被卡住以后,后面的所有的都没法进行下去了。所以我们整个项目也差不多中止有一年的时间,后来我们花了很大的力气才把这个问题给解决,现在我们用的分级组装和后续改造来实现了整条染色体的拼接,一边解决问题,一边菌株还可以不断的往后构建。
图:3月9日,戴俊彪博士在清华大学生命科学学院实验室里展示培养皿中的酿酒酵母菌株。(图片来源:新华社)
合成基因组的应用前景和挑战
【基因慧】:据称,Sc2.0可以作为工具导入外源基因后,生成胡萝卜素等,甚至说人工基因组也有可能带来寒武纪时代的物种爆发,您作为一个科学家,能够和基因慧读者分享下,这项技术对于生物制药、医学诊疗、生物能源和信息存储等方面会带来怎样的影响呢?从技术转化到工业生产中的挑战是?前景如何?
【戴俊彪】:我觉得人工基因组合成的技术在如今或者未来的这段时间内应该会有一些很好的应用。比如这一两年就可以实现的是我们可以利用合成的这个菌株,用于替代或改进现有的酵母来进行发酵生产,比如说生产β-胡萝卜素,青蒿素等,或者比如说用酵母发酵来做生物乙醇等等。此外,还可以利用我们合成的酵母, 对这些应用的产量以及产率进行进一步提高,实现更大的经济价值。在生物能源和信息领域都会有它的前景。
当然其中还有很多的挑战。比如怎么样能够去理性的设计我们的基因组。因为现在我们对基因组所决定的表型或者决定这样生物学的功能所知道的还非常有限,在科学上其实还有很多未知的东西。假如我们连这东西是什么或者怎么样实现都不知道,那么你想去设计它将是非常大的一个挑战。所以我们现在能够做的或者技术上能够做的就是通过我们去构建它,然后通过不断的后续表型的分析,高通量的测序去发现新的问题。针对发现的问题去研究生物上机理是什么,然后再根据这机理,再去设计,再去应用。所以Sc2.0整个基因设计与合成可以加深我们对生物遗传物质的整体信息的理解,同时在基础科研和应用上寻得出路。我对基因组合成应用的前景还是非常看好的。合成生物学涉及很多领域,对整个生物产业将会有很大的促进。
我每次在清华上课都有这样的感觉,现在是一个非常好的时间点,因为我们已经把测序技术发展到了极致,现在可以测各式各样的生物,甚至世界上所有的生物未来也许都会被序列分析出来,从而为我们打开了一个巨大的资源宝库——基因宝库。那么通过测序,知道基因信息以后怎么样利用去做一些事情呢,就是一个从测序到合成的过程。我想我们可以通过“写”的办法去设计很多的生物,来实现很多各种应用中所需要的功能。
我也希望我们的读者,以及更多的大众可以关心合成生物学的发展,同时也能够允许给我们一个发展的时间和空间,让科学家们能够更好的完善、发展各项技术,使得这项技术能够真正的应用于民,为整个社会的发展创造一些福利。能够对我们的各个方面包括在医疗卫生、健康、环境污染的改造、能源危机的化解等方面做出贡献。
这些是我个人对于这个领域对于我们做的一些工作的想法和借鉴,然后我也希望我们中国未来的合成生物学能够做的更好,能够在世界上能够拿出去和别人竞争,可以赢得产业的先机,如果有不正确的地方还请大家多多谅解。谢谢大家!
【参考资料及相关文献附后】
嘉宾专享
作者主页:
http://life.tsinghua.edu.cn/faculty/faculty/1594.html

青兰生物
全基因合成服务首选
更多干货(点击超链接可见,非超链接关注下述公众号可见)
(更多内容请关注以下姊妹公众号)

参考资料及文献:
1.http://scitech.people.com.cn/n1/2017/0310/c1007-29135176.html
2.Engineering the ribosomal DNA in a megabase synthetic chromosome
3. Junbiao Dai*, Edel M. Hyland*,Daniel S. Yuan, Hailiang Huang, Joel S. Bader and Jef D. Boeke, ProbingNucleosome Function: A Highly Versatile Library of Synthetic Histone H3 and H4Mutants,Cell, 2008, 134: 1066-1078 (Featured cover story).
4.Synthetic chromosome arms function in yeast and generate phenotypic diversity by design
声明
1. 以上内容是基因慧独立策划、编辑成文。版权属于基因慧,在尊重版权情况下,欢迎转发。转载请注明:来源于基因慧。
2.基因慧是一家第三方独立的行业信息服务和知识服务公司,我们秉持客观、严谨、中立的态度,从多方渠道收集并发布信息,供行业参考。但受收集当时信息公开的时效性,不同渠道存在不同见解,不能完全保证信息的完整性和准确性,如有错漏之处,欢迎指正。
行研、咨询、会议、品宣等服务:
电话:010-56527551 / 400-088-7466
地址:北京市海淀区中关村大街1号
官网:www.geneclub.net.cn
邮箱:info@genonet.cn
基因慧
精准医疗
行业连接器
长按关注
